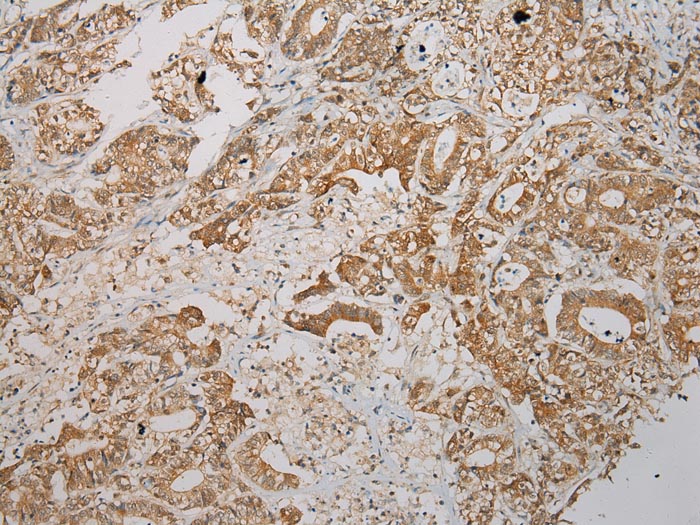

Immunohistochemistry analysis in human lymph node and testis tissues using AMAb90616 antibody. Corresponding STX7 RNA-seq data are presented for the same tissues.
Anti-STX7 Antibody
AMAB90616
ApplicationsWestern Blot, ImmunoCytoChemistry, ImmunoHistoChemistry
Product group Antibodies
ReactivityHuman
TargetSTX7
Overview
- SupplierAtlas Antibodies
- Product NameAnti-STX7 Antibody
- Delivery Days Customer4
- ApplicationsWestern Blot, ImmunoCytoChemistry, ImmunoHistoChemistry
- CertificationResearch Use Only
- ClonalityMonoclonal
- Clone IDCL0257
- ConjugateUnconjugated
- Gene ID8417
- Target nameSTX7
- Target descriptionsyntaxin 7
- Target synonymssyntaxin-7
- HostMouse
- IsotypeIgG1
- Protein IDO15400
- Protein NameSyntaxin-7
- Scientific DescriptionRecombinant Protein Epitope Signature Tag (PrEST) antigen sequence
- ReactivityHuman
- Storage Instruction-20°C,2°C to 8°C
- UNSPSC41116161
![Lane 1: Marker [kDa]. Lane 2: Human tonsil tissue lysate Lane 1: Marker [kDa]. Lane 2: Human tonsil tissue lysate](https://atlasantibodies.s3.amazonaws.com/images/wb/amab90616-wb-1.jpg)